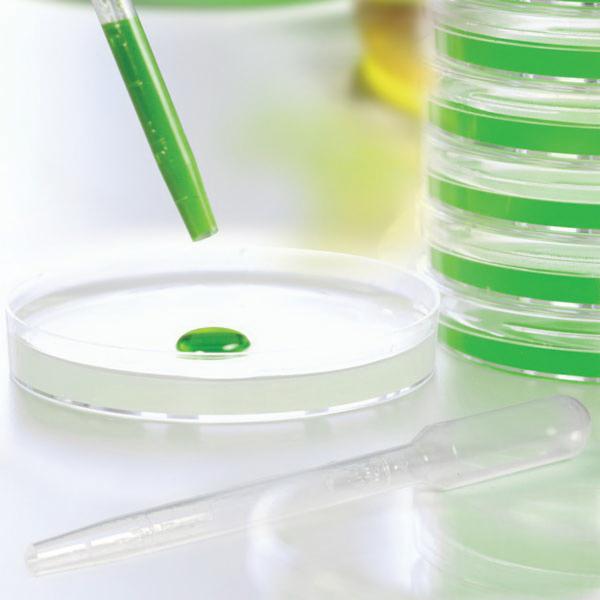

Globe Scientific Individually Wrapped Sterile Wide Bore Graduated Tip Transfer Pipet, 7 ml, 125 mm L
Transfer Pipet, 7 ml, 7.9 mm Stem Diameter, 5.5 mm Tip Internal Diameter, LDPE, Large Bulb, Wide Bore, Graduated Tip, Sterile, -50 to 90°C Temperature Range, Disposable, Graduated up to 3 ml, 0.5 ml Graduation Increments, Individually Wrapped
- Manufacturer Part No: 135040-S01
- SECO Part No: GLB-135040-S01
- Sold As:
-
Availability:

Login to View Your Price
-
List Price :

Globe Scientific offers the most extensive line of plastic transfer pipets for liquid handling procedures. Produced from a custom grade of low-density polyethylene (LDPE), these unbreakable one-piece pipets are used to draw and dispense liquids in controlled, reproducible drop sizes. Plastic transfer pipets are the perfect substitute for breakable glass Pasteur pipets, which can be a danger to laboratory personnel. And, because they are completely disposable, there is never any cross-contamination which is associated with reusable rubber bulbs. An extensive selection of capacities, lengths and tip styles are offered to accommodate different industry needs. For the rapid and effective transfer of viscous liquids and small particulates. These wide bore transfer pipets feature a wide tip opening designed specifically for the transfer of viscous liquids and small particulates. They are useful in the biofuel, petroleum, water treatment, food/beverage and pathology industries.
| Capacity | : | 7 ml |
| Size | : | Large Bulb |
| Length | : | 125 mm |
| Material (ml/min) | : | LDPE |
| Graduated Up To | : | 3 ml |
| Graduation Intervals | : | 0.5 ml |
| Stem Diameter | : | 7.9 mm |
| Sterility | : | Sterile |
| Style | : | Wide Bore, Graduated Tip |
| Temperature Range | : | −50 to 90°C |
| Tip Diameter | : | 5.5 mm ID |
| Usage | : | Disposable |
- Non-toxic and chemically inert to biological fluids and most acids
- Can be heat sealed to use for liquid storage or transport
- Pipets can be frozen in liquid nitrogen
- Produced from a custom grade of low-density polyethylene (LDPE) to make them non-slippery, this makes Globe Scientific pipets easy to grip with gloves
- Designed for measurements, these pipets feature molded-in graduation marks that will never fade or wash off
- Ideal for transferring: Algae, sludge, oil, slurry, small tissue biopsies and, plant specimens pleural specimens, sauces, gravies, syrup and condiments
- Ideal alternative to forceps for use with small to minute biopsies
- Single use pipet eliminates potential for specimen-to-specimen contamination
- Eliminates specimen trauma associated with excessive forceps pressure
- Also suitable for transfer of pleural specimens and other viscous liquids
- Can be gas (EtO) sterilized
- Individually wrapped

Catalog
Catalog